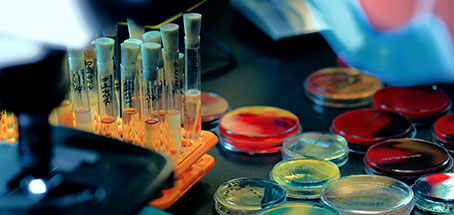

我们为您提供技术服务

-

成分分析
通过微谱分析,对目标样品的基础组分进行分析,提供目标样品的全成分分析报告(成分组成+成分定性定量依据)
咨询工程师 -

配方分析研发
微谱通过光谱、色谱、核磁等精密仪器分析样品成分的化学名称和成分含量,还原配方
咨询工程师 -
性能改进提升
产品性能不达标,客户只需要提供高性能样品,我们可以对样品进行分析,配方改进,提高产品性能
咨询工程师 -

失效分析诊断
通过微谱分析,对正常样品和失效样品进行测试分析,推测失效原因,提供失效分析报告及改善措施
咨询工程师 -

标准检测服务
微谱实验室为多领域产品提供国家标准,行业标准,国际标准等检测服务
咨询工程师 -

仪器测试服务
微谱拥有各种大型精密仪器,借助准确测试方法和专业技术工程师,为各类企业提供专业的分析测试服务
咨询工程师
微谱服务案例

- 橡胶白色喷霜解决
- 阻燃剂配方分析
- 处理剂成分分析
客户背景:
某橡胶公司生产的鞋底放置2个月后,出现白色喷霜现象,由于不清楚 喷霜异物成分,无法解决问题,导致市场销售面临严重危机。
解决方案:
1、微谱工程师与客户沟通后,推测是鞋底配方问题;
2、确定具体原因,制定分析方案,对异物提取测试;
3、依据分析结果及样品性能要求,工程师给出调整方案,提高了胶料对助剂的溶解度。
客户反馈:
客户根据建议,经过几次调试,做出的产品放置6个月仍不喷霜,产品得到市场的一致认可,并收到大量的产品订单。
客户背景:
某TPE线缆生产商,阻燃剂用量巨大,成想自己研发生产,却苦于缺乏技术支持。
解决方案:
1、调研了解,确定分析方案;
2、通过微谱工程师仪器测试,确认客户原阻燃剂成分;
3、分析确定三种主体阻燃剂物质,得到基础配方。
客户反馈:
客户拿到样品配方后,成功调试出产品,每月为客户带来几十万的利润。
客户背景:
国内某大型电镀厂,客户因为关键原材料信息缺失加上原材料成本和购买周期问题,一直受制于国外公司。
解决方案:
通过IR、NMR、MS、XRF、GC-MS对样品进行基本种类确定,再通过Py-GCMS、GPC、Maldi-tof、Q-TOF对样品的合成单体、分子量和结构链结进行确定。
客户反馈:
通过我们提供的合成单体和分子量信息,在国内找到合适的原材料,并且客户下一步准备自己合成生产该原材料,用来节省成本和提高自己的核心竞争力。
关于我们


微谱,大型研究型检测机构,始于2008年,总部位于上海,是科技服务改变世界的践行者。
微谱聚焦先进制造、生物医药、美丽健康、生态环保、食品农产品五大领域,向社会提供分析测试、检测评价、研发服务、计量校准、认证审核、知识产权六大服务,全方位的技术解决方案助力客户取得更大成功。
微谱现已在全国30多个城市设立分子公司以及50多个专业实验室,拥有3000余名专业人员。微谱是中国合格评定国家认可委员会(CNAS)认可的、市场监督管理局资质认定(CMA)的综合性第三方检验检测机构,也是国家药品监督管理局批准的化妆品注册和备案检验检测机构,具有海关总署颁发的进出口商品检验鉴定机构资格,也拥有农产品CATL(农产品质量安全检测)资质,实验动物使用许可证,病原微生物BSL-2实验室,ISO9001质量管理体系认证等。同时微谱也是国家工业和信息化部认定的国家产业技术基础公共服务平台、国家服务型制造示范平台、国家专精特新小巨人企业。基于十七年的专业技术积累和遍布全国的服务网络,微谱每年出具超过45万份技术报告,累计服务客户49万余家,其中包括世界五百强客户百余家。
微谱始终秉承“ 服务,不止于检测! ”的理念,尽心尽力让科技进步更快,让产品质量更好,让人类生活更安全、更健康、更绿色!
*以上提及的资质、荣誉等相关数据来源:微谱科技集团旗下分子公司及其关联公司;以上提及的各项业务,由拥有相应业务资质的微谱科技集团旗下分子公司及其关联公司承接;其中专利代理业务由上海微略知识产权代理有限公司全权受理。
只需4步轻松解决需求

FOUR STEPS TO SOLVE
-

1.
欢迎您与工程师电话沟通业务需求或来公司实验室考察
-

2.
寄送样品或工程师上门取样签订合同
-

3.
仪器分析检测样品,工程师汇总数据报告
-

4.
为您寄送报告,工程师主动售后回访,解决您的售后疑惑
 关闭
关闭
弹窗





















